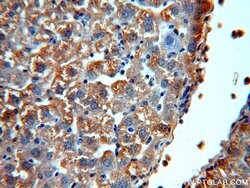
Alpha galactosidase A Rabbit anti-Human, Mouse, Rat, Polyclonal, Proteintech:Antibodies:Primary

missing translation for 'onlineSavingsMsg'
Learn More
Learn More
Alpha galactosidase A Rabbit anti-Human, Mouse, Rat, Polyclonal, Proteintech
Rabbit Polyclonal Antibody
£135.00 - £349.00
Specifications
| Antigen | Alpha galactosidase A |
|---|---|
| Concentration | 0.16 mg/mL |
| Applications | Immunoprecipitation, Immunohistochemistry (Paraffin), Western Blot |
| Classification | Polyclonal |
| Conjugate | Unconjugated |
| Product Code | Brand | Quantity | Price | Quantity & Availability | |||||
|---|---|---|---|---|---|---|---|---|---|
| Product Code | Brand | Quantity | Price | Quantity & Availability | |||||
|
16874594
|
Proteintech
15428-1-AP-20UL |
20 μL |
£135.00
20µL |
Please sign in to purchase this item. Need a web account? Register with us today! | |||||
|
16864594
|
Proteintech
15428-1-AP-150UL |
150 μL |
£349.00
150µL |
Please sign in to purchase this item. Need a web account? Register with us today! | |||||
Description
This gene encodes a homodimeric glycoprotein that hydrolyses the terminal alpha-galactosyl moieties from glycolipids and glycoproteins. This enzyme predomitly hydrolyzes ceramide trihexoside, and it can catalyze the hydrolysis of melibiose into galactose and glucose. A variety of mutations in this gene affect the synthesis, processing, and stability of this enzyme, which causes Fabry disease, a rare lysosomal storage disorder that results from a failure to catabolize alpha-D-galactosyl glycolipid moieties.Specifications
| Alpha galactosidase A | |
| Immunoprecipitation, Immunohistochemistry (Paraffin), Western Blot | |
| Unconjugated | |
| Rabbit | |
| Rat, Mouse, Human | |
| P06280, P51569 | |
| 11605, 2717, 363494 | |
| Alpha galactosidase A Fusion Protein Ag7609 | |
| Primary | |
| -20°C | |
| GLA |
| 0.16 mg/mL | |
| Polyclonal | |
| Liquid | |
| RUO | |
| PBS with 50% glycerol and 0.02% sodium azide; pH 7.3 | |
| Alpha galactosidase A, galactosidase, alpha | |
| GLA | |
| IgG | |
| Antigen Affinity Chromatography | |
| Antibody |
Spot an opportunity for improvement?Share a Content Correction
Product Content Correction
Your input is important to us. Please complete this form to provide feedback related to the content on this product.
Product Title